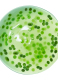
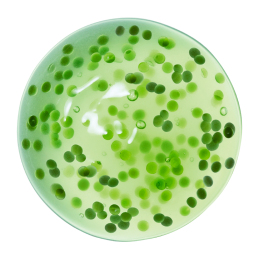

TOP ΑΝΑΖΗΤΗΣΕΙΣ
CHRISTMAS GIFTS

+ Δωρο

CREMA NERA REVISCENTALIS META CONCENTRATE SERUM
Κωδικός προϊόντος: 00000090605
CHRISTMAS OFFER
521,17 €
ΕΝΗΜΕΡΩΣΗ ΔΙΑΘΕΣΙΜΟΤΗΤΑΣ
Προστέθηκε στα αγαπημένα
Αφαιρέθηκε από τα αγαπημένα
CHRISTMAS OFFER
*Εξαιρείται η Συλλογή Armani Privé με -20% με αγορές 2 και άνω προϊόντων. -35%με αγορές 2 και άνω προϊόντων.
Ισχύει συνδυαστικά για τα Brands Lancôme, Yves Saint Laurent, Armani, Kiehl's, Valentino, Prada, Mugler και Biotherm.
*Εξαιρούνται οι Συλλογές Valentino Anatomy of Dreams, Prada Olfactories και επιλεγμένοι κωδικοί.
*Η ενέργεια ΔΕΝ ισχύει σε όλους τους κωδικούς παρά μόνο σε όσους εμφανίζεται το συγκεκριμένο μήνυμα.
Περιγραφή
Το Crema Nera Reviscentalis Meta Concentrate Serum 30ml από τον οίκο Giorgio Armani υποστηρίζει την ανανέωση των κυττάρων της επιδερμίδας, χαρίζοντας της μία αίσθηση άμεσης προστασίας μετά από λίγες μόνο σταγόνες. Σχεδιασμένο με Reviscentalis - συστατικό που εξάγεται από ένα φυτό που είναι διάσημο για την ικανότητά του να παίρνει ξανά ζωή ακόμα και όταν φτάνει στα πρόθυρα της πλήρους αποξήρανσης, χάρη στον εξαιρετικό μεταβολισμό του - αυτό το serum αναμφίβολα θα σας χαρίσει πιο φωτεινή επιδερμίδα και θα μειώσει την εμφάνιση ρυτίδων.
Με την υπογραφή Armani
Με την υπογραφή Armani
Οδηγίες Χρήσης & Προφύλαξης
Απλώστε σε ολόκληρο το πρόσωπο με κυκλικές κινήσεις.
Συστατικά
AQUA / WATER, BUTYLENE GLYCOL, ISOPROPYL LAUROYL SARCOSINATE, GLYCERIN, DIPROPYLENE GLYCOL, CAPRYLIC/CAPRIC/SUCCINIC TRIGLYCERIDE, HYDROXYACETOPHENONE, ACRYLATES/C10-30 ALKYL ACRYLATE CROSSPOLYMER, CHLORPHENESIN, CAPRYLYL GLYCOL, PEG-240/HDI COPOLYMER BIS-DECYLTETRADECETH-20 ETHER, PENTYLENE GLYCOL, ASCORBYL TETRAISOPALMITATE, CAPRYLOYL SALICYLIC ACID, FERULIC ACID, SODIUM ACETYLATED HYALURONATE, TRISODIUM ETHYLENEDIAMINE DISUCCINATE, TOCOPHEROL, POTASSIUM HYDROXIDE, TREHALOSE, AGAR, ADENOSINE, XANTHAN GUM, CERATONIA SILIQUA GUM / CAROB GUM, PEG-30 DIPOLYHYDROXYSTEARATE, TRIDECETH-6, ALGIN, PENTAERYTHRITYL TETRA-DI-T-BUTYL HYDROXYHYDROCINNAMATE, MYROTHAMNUS FLABELLIFOLIA LEAF EXTRACT, HELIANTHUS ANNUUS SEED OIL / SUNFLOWER SEED OIL, POTASSIUM CHLORIDE, ARGININE, SERINE, RHAMNOSE, MAGNESIUM SULFATE, LINALOOL, HEXYL CINNAMAL, SODIUM LACTATE, BENZYL SALICYLATE, ALPHA-ISOMETHYL IONONE, BENZYL ALCOHOL, CITRONELLOL, GERANIOL, CI 19140 / YELLOW 5, HAEMATOCOCCUS PLUVIALIS EXTRACT, HYDROLYZED SOY PROTEIN, CI 61570 / GREEN 5, CI 61565 / GREEN 6, CAPRYLIC/CAPRIC TRIGLYCERIDE, POTASSIUM LAURATE, FAGUS SYLVATICA BUD EXTRACT, CERAMIDE NP, CI 17200 / RED 33, CI 40800 / BETA-CAROTENE, BENZOIC ACID, SORBIC ACID, PARFUM / FRAGRANCE. (F.I.L. B247824/1)
Στοιχεία Επικοινωνίας Προμηθευτή
Για επικοινωνία με τον προμηθευτή L'Oreal Grupe:
Ταχυδρομική διεύθυνση: Giorgio Armani, 14, rue Royale - 75008 Paris France
Διεύθυνση URL της ενότητας «Επικοινωνία» του ιστοτόπου της L'Oreal: consumercaregreece@loreal.com
Διαβάστε περισσότερα για τους Tρόπους Παράδοσης & τις Επιστροφές
- ΜΠΟΡΕΙ ΝΑ ΣΑΣ ΑΡΕΣΕΙ ΑΚΟΜΗ
- ΕΙΔΑΤΕ ΠΡΟΣΦΑΤΑ


















































